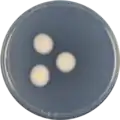

Aspergillus luppii
Aspergillus luppii (also called A. aureofulgens) is a species of fungus in the genus Aspergillus.[1][2][3] It is from the Flavipedes section.[4] Aspergillus luppii produces the antimicrobics Curvularin and Dehydrocurvularin.[5][6]
| Aspergillus luppii | |
|---|---|
| Scientific classification | |
| Kingdom: | Fungi |
| Division: | Ascomycota |
| Class: | Eurotiomycetes |
| Order: | Eurotiales |
| Family: | Trichocomaceae |
| Genus: | Aspergillus |
| Species: | A. luppii |
| Binomial name | |
| Aspergillus luppii | |
| Type strain | |
| CBS 653.74, CCF 4545, NRRL 6326, NRRL MOLD 6326, PRM 923447[2] | |
| Synonyms | |
|
Aspergillus aureofulgens | |
Growth and morphology
A. luppii has been cultivated on both Czapek yeast extract agar (CYA) plates and Malt Extract Agar Oxoid® (MEAOX) plates. The growth morphology of the colonies can be seen in the pictures below.
Aspergillus luppii growing on CYA plate
Aspergillus luppii growing on CYA plate Aspergillus luppii growing on MEAOX plate
Aspergillus luppii growing on MEAOX plate
References
- "Aspergillus aureofulgens". www.mycobank.org.
- "Aspergillus luppii". www.uniprot.org.
- "A. aureofulgens | Aspergillus & Aspergillosis Website". www.aspergillus.org.uk.
- Hubka, Vit; Nováková, Alena; Kolarik, Miroslav; Jurjevic, Zeljko; Peterson, Stephen W. (2015). "Revision of Aspergillus section Flavipedes: seven new species and proposal of section Jani sect. nov". Mycologia. 107 (1): 169–208. doi:10.3852/14-059. PMID 25344259.
- Fugmann, Burkhard; Lang-Fugmann, Susanne; Steglich, Wolfgang (2014). RÖMPP Encyclopedia Natural Products, 1st Edition, 2000. Georg Thieme Verlag. ISBN 9783131795519.
- Betina, V. (1993). Chromatography of Mycotoxins: Techniques and Applications. Elsevier. ISBN 9780080858623.
Further reading
- Caputo, O.; Viola, F. (1977). "Isolation of a, beta-dehydrocurvularin from Aspergillus aureofulgens". Planta Medica. 31 (1): 31–32. doi:10.1055/s-0028-1097485. ISSN 0032-0943. PMID 840925.
- Gesellschaft für Arzneipflanzenforschung (Germany), Deutsche Gesellschaft für Arzneipflanzenforschung (1977). Planta medica. Hippokrates-Verlag.
- Laskin, Allen I.; Lechevalier, Hubert A.; Company, Chemical Rubber (1988). CRC Handbook of Microbiology: pt. A. Antibiotics. CRC Press.
This article is issued from Wikipedia. The text is licensed under Creative Commons - Attribution - Sharealike. Additional terms may apply for the media files.